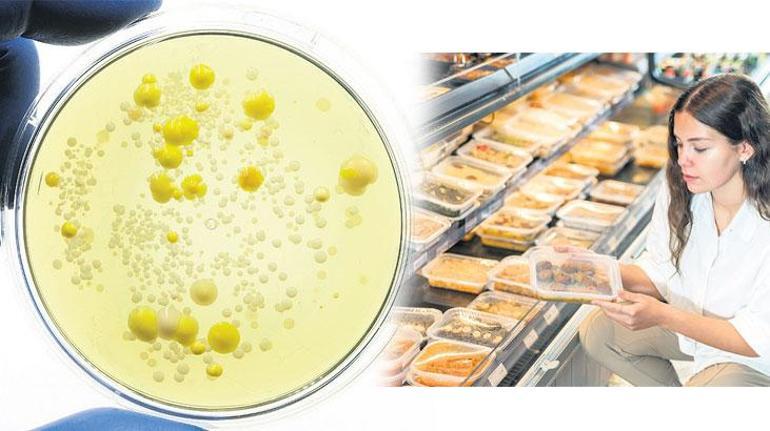

Et ve Süt Kurumu Dergisi’nden Çarpıcı Araştırma: Hipermarketlerde Satılan Gıdalarda Bakteri Tehlikesi!
Et ve Süt Kurumu’nun dergisinde yayınlanan bir çalışma, hipermarketlerde satılan gıdalardaki potansiyel tehlikeyi gün yüzüne çıkardı. Tavuk döner, kadınbudu köfte, kremalı yaş pasta, keşkül gibi ürünlerde, gıda zehirlenmelerine sebep olabilecek “staphylococcus aureus” adlı bakterinin varlığı tespit edildi. Ankara’da satışı yapılan bazı tüketime hazır gıdalarda, zehirlenmelere yol açabilen bu bakteri türü incelendi.
Analiz Sonuçları Şaşırtıcı!
Farklı hipermarketlerden alınan örnekler incelendi ve Rus salatası, İtalyan salatası, tavuk salatası, kadınbudu köfte, Arnavut ciğeri, tavuk döner, kremalı yaş pasta, kazandibi ve keşkülde yüzde 5’lik oranda “aureus” bakterisinin varlığı belirlendi. Arnavut ciğerinde yüzde 10, keşkülde yüzde 15, kremalı yaş pastada ise yüzde 20 oranında söz konusu bakteriye rastlandı. Rus ve İtalyan salatalarında ise herhangi bir bakteriye rastlanmadı.
Hijyen Konusunda Uyarı!
Çalışma sonuçları, halk sağlığı açısından son derece önemli olduğunu gösterdi. Tüketime hazır gıdalarda bakteri riskini minimize etmek için gıda işletmelerinin personel hijyenine önem vermesi ve gıda güvenliği sistemlerini uygulaması gerektiği vurgulandı.
Denetimler Devam Ediyor
Tarım ve Orman Bakanlığı, halk sağlığını tehdit eden gıdaları denetlemeye devam ederek bu yıl 900 binden fazla gıda denetimi gerçekleştirdi. Sağlığı riske atacak gıdalar ve taklit ürünler konusunda denetimlerin sürdüğü belirtildi.